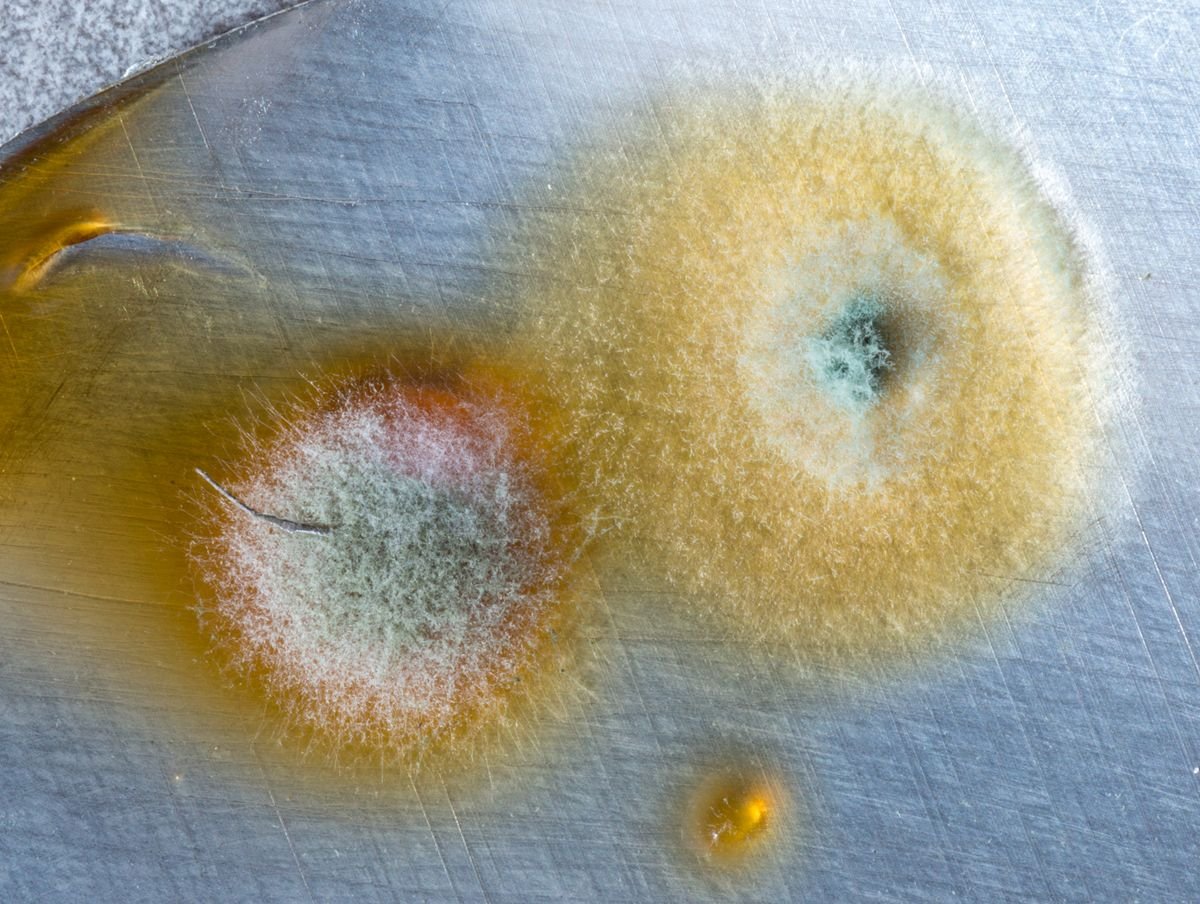

The quest for increased height has led to the development of various height growth capsules, promising a natural and effective solution for those seeking to add a few extra inches. This article delves into the science behind these capsules, exploring their ingredients, biological mechanisms, and the clinical evidence supporting their use. We also provide practical guidance for consumers and look ahead to future advancements in height enhancement.
Key Takeaways
- Height growth capsules often contain supplements and ingredients aimed at supporting natural growth processes, but their effectiveness varies.
- Human Growth Hormone (HGH) plays a crucial role in growth, and these capsules may aim to stimulate its production, but genetics and nutrition are also key factors.
- Clinical research provides insight into the efficacy and safety of growth capsules, though more studies are needed to confirm long-term effects.
- Consumers should carefully evaluate growth capsules, considering factors like ingredients, dosage, and certification standards to ensure quality and safety.
- Emerging therapies and genetic engineering present new frontiers for height enhancement, but they also raise ethical and regulatory questions.
Understanding Height Growth Capsules
The Role of Supplements in Growth
Height growth capsules are often marketed as a convenient solution for those seeking to increase their stature. The allure of a simple pill that can enhance one’s height is compelling, but it’s essential to understand the role these supplements play in growth.
Supplements are not a magic solution; they work by providing the body with the necessary nutrients that may support the natural growth process. For instance, they might contain vitamins and minerals that are crucial for bone health and development. However, it’s important to use supplements with caution, as their efficacy can vary greatly.
While some individuals may experience modest height increases, others may not see any change at all.
The following list outlines key considerations when contemplating the use of height growth capsules:
- The age and growth stage of the individual
- The specific ingredients and their concentrations in the supplement
- The presence of any underlying health conditions
- The recommended dosage and duration of use
Before turning to height growth capsules, it’s advisable to consult with a healthcare professional to assess their potential benefits and risks.
Active Ingredients and Their Functions
Height growth capsules often contain a blend of vitamins, minerals, and other compounds that are essential for bone health and growth. The efficacy of these capsules largely depends on the active ingredients they contain. For instance, calcium and vitamin D are critical for bone density and strength, while amino acids like L-arginine can stimulate the production of human growth hormone (HGH), which is vital for growth.
- Calcium: Essential for bone mineralization and strength.
- Vitamin D: Facilitates calcium absorption and bone growth.
- L-arginine: A precursor to HGH, supports muscle and bone development.
It’s important to note that while these ingredients can support growth, they cannot guarantee significant height increases, especially after the natural growth period has ended.
When considering height growth capsules, it’s crucial to look beyond marketing claims and evaluate the scientific backing of the ingredients. Some products may also include herbal extracts or other substances with less clear effects on height. Always consult with a healthcare provider before starting any new supplement regimen.
Differentiating Between Myths and Facts
In the realm of height growth, misinformation can often overshadow scientific evidence. It is crucial to differentiate between myths and facts to make informed decisions about using height growth capsules. For instance, a common misconception is that individuals cannot grow taller after puberty; however, certain supplements may support bone health and density even in adulthood.
Myth vs. Fact:
- Myth: You cannot grow taller after puberty.
- Fact: Some adults may experience slight increases in height through proper nutrition and supplementation.
- Myth: You need to drink lots of milk to grow taller.
- Fact: While calcium is important, overall nutrition is what supports growth.
- Myth: Lifting weights will stunt your growth.
- Fact: Strength training, when done correctly, does not impede height.
While no supplement can guarantee significant height increases, debunking myths can guide consumers towards products that support their overall bone health and posture. It’s important to approach height growth capsules with realistic expectations and a clear understanding of what they can and cannot do.
Biological Mechanisms of Height Increase
Human Growth Hormone (HGH) Explained
Human Growth Hormone (HGH) is a critical peptide hormone that stimulates growth, cell reproduction, and cell regeneration in humans. It plays a pivotal role in human development, particularly during childhood and adolescence. HGH is naturally produced by the pituitary gland and its levels in the body can significantly influence height.
HGH supplements and height growth capsules often claim to boost the body’s natural production of the hormone. However, the effectiveness of these supplements can vary widely. Here’s a brief overview of how HGH functions:
- Stimulates the liver to produce insulin-like growth factor 1 (IGF-1), which promotes growth in bone and other tissues.
- Affects the metabolism of proteins, fats, and carbohydrates, contributing to overall body composition.
- Helps to regulate muscle and bone growth, especially during the rapid growth phases of childhood and puberty.
While HGH can be a powerful influencer of growth, its effectiveness when taken as a supplement is subject to individual factors such as age, genetics, and existing levels of hormone production.
It’s important for consumers to approach HGH supplements with caution and to seek professional medical advice before starting any new treatment. The market is rife with products making bold claims, and not all are backed by scientific evidence.
The Impact of Nutrition on Bone Growth
Proper nutrition plays a pivotal role in the development of strong and healthy bones, which is essential for achieving optimal height. Calcium and vitamin D are fundamental nutrients that support bone growth and density. Without adequate levels of these nutrients, bone development may be compromised, potentially affecting overall height.
Protein is another key nutrient that contributes to bone growth and repair. Amino acids from protein are the building blocks of bone tissue, and a deficiency in protein can lead to weakened bone structure and growth issues.
- Calcium: Essential for bone mineralization
- Vitamin D: Facilitates calcium absorption
- Protein: Provides building blocks for bone tissue
- Phosphorus: Works with calcium to strengthen bones
- Magnesium: Involved in bone formation and mineralization
Ensuring a balanced diet rich in these nutrients is crucial for individuals aiming to maximize their height potential. It is not only the presence of these nutrients that matters but also their proper balance and the timing of their intake during the growth phases.
While nutrition is a key factor, it is important to remember that it is one of several elements that contribute to height growth. Genetic factors and overall health also play significant roles in determining an individual’s final stature.
Genetics vs. Environment: What Matters More?
The debate between genetics and environment in determining height is ongoing, with evidence supporting the influence of both factors. Genetic makeup is undoubtedly a significant determinant of an individual’s potential for growth, as it sets the foundational blueprint for height. However, environmental factors such as nutrition, health during childhood, and physical activity play crucial roles in realizing this genetic potential.
Environmental influences can either promote or hinder growth, depending on the quality and availability of resources. For instance, a child with a genetic predisposition for tall stature may not reach their full height potential if they experience malnutrition or chronic illness.
While genetics provide the framework for height, it is the environment that fills in the details, allowing individuals to achieve their maximum growth potential.
Understanding the interplay between genetics and environment is essential for evaluating the effectiveness of height growth capsules. These supplements may offer benefits, but they cannot override one’s genetic limits. Here’s a simple list to consider when assessing the impact of genetics and environment on height:
- Genetic factors determine the potential range of an individual’s height.
- Environmental factors influence whether an individual will reach the upper limit of their genetic height potential.
- Height growth capsules may support the environmental aspect of growth, but they cannot change genetic predispositions.
Clinical Evidence and Research
Studies on the Efficacy of Growth Capsules
Numerous studies have been conducted to assess the efficacy of height growth capsules, with varying results. The consensus indicates that while some supplements may offer marginal benefits, they are largely dependent on individual factors such as age and genetic predisposition.
Clinical trials have played a crucial role in understanding the potential and limitations of these supplements. For instance, a study on a popular growth capsule showed the following results:
| Age Group | Average Height Increase | Placebo Group Increase |
|---|---|---|
| 10-15 | 1.2 cm | 0.5 cm |
| 16-20 | 0.8 cm | 0.3 cm |
It’s important to note that these increases are modest and should be weighed against the potential risks and costs associated with long-term use.
While growth capsules can contribute to height increase, they should not be seen as a standalone solution. Balanced nutrition, adequate sleep, and regular exercise are essential for optimal growth during the developmental years.
Long-Term Effects and Safety Concerns
The allure of height growth capsules often overshadows the need for a thorough understanding of their long-term effects and safety concerns. Long-term safety is a critical aspect that cannot be overlooked when considering the use of such supplements. While some products, like Speed Height Capsule, claim to promote height increase and bone density improvement, they may also bring potential side effects.
Potential side effects include digestive issues, allergic reactions, and hormonal imbalances. It is imperative for users to consult a healthcare professional before starting any supplement regimen.
The following list outlines common concerns associated with the long-term use of height growth capsules:
- Monitoring for adverse reactions over time
- Assessing the impact on natural growth patterns
- Evaluating the risk of dependency or withdrawal symptoms
- Understanding the implications on overall health and development
Comparing Traditional and Emerging Therapies
In the realm of height enhancement, traditional therapies have largely revolved around hormone treatments and nutritional supplements. However, emerging therapies are gaining traction, offering innovative approaches to stimulating growth. One such therapy is the use of Somapacitan, a long-acting growth hormone that is administered once weekly, showing promise in terms of efficacy and patient adherence.
Traditional therapies often require daily interventions, which can be cumbersome for patients. In contrast, emerging therapies aim to reduce the frequency of administration while maintaining or improving treatment outcomes. This shift not only enhances convenience but also potentially improves the psychological well-being of individuals undergoing treatment.
The comparison between traditional and emerging therapies is not just about efficacy, but also about the quality of life improvements they offer.
While traditional therapies have a longer track record, the scientific community is keenly observing the long-term effects of newer treatments. It is crucial to balance the excitement for innovation with rigorous clinical evaluation to ensure safety and effectiveness.
Consumer Guide to Height Growth Capsules
How to Choose the Right Supplement
Selecting the appropriate height growth capsule can be a daunting task given the plethora of options available. It is essential to consider the supplement’s composition, the credibility of the manufacturer, and the presence of clinical evidence supporting its efficacy. Look for products that have a transparent ingredient list and are backed by scientific research.
When evaluating supplements, pay attention to the concentration of active ingredients. A higher concentration does not always equate to better results, and in some cases, it may lead to adverse effects. Here’s a simple checklist to guide you through the selection process:
- Verify the supplement’s regulatory approval status.
- Check for any known side effects or interactions with other medications.
- Assess the reputation of the brand and read consumer reviews.
- Consult with a healthcare professional before starting any new supplement regimen.
Remember, a well-informed decision is your best defense against ineffective or harmful products. While some supplements may promise quick results, sustainable height growth is a gradual process that relies on a combination of factors, including nutrition, exercise, and genetics.
Understanding Dosage and Administration
Proper dosage and administration are crucial for the effectiveness of height growth capsules. Always follow the manufacturer’s guidelines to ensure safety and optimal results. The recommended dosage can vary based on factors such as age, weight, and individual health conditions.
Consistency is key when taking supplements. It’s important to maintain a regular schedule to allow the active ingredients to work effectively over time. Missing doses or irregular consumption can hinder the potential benefits of the capsules.
While no universal dosage fits all, consulting with a healthcare provider can help tailor the regimen to your specific needs.
Here is a general guideline for administration:
- Take the capsules with a full glass of water.
- Consume the capsules at the same time each day.
- Avoid taking with high-caffeine or alcoholic beverages as they may interfere with absorption.
- If you experience any adverse effects, discontinue use and consult a healthcare professional immediately.
Recognizing Quality and Certification Standards
When considering height growth capsules, it’s crucial to recognize the importance of quality and certification standards. Ensuring that the product meets regulatory requirements is not just about legality; it’s about safety and efficacy. Look for certifications from recognized bodies such as the FDA or GMP (Good Manufacturing Practices), which indicate that the product has been manufactured to high standards.
Certification is a testament to the manufacturer’s commitment to quality. However, not all certifications are created equal. It’s essential to understand what each certification means and what it covers. For instance, an organic certification may imply that the ingredients are free from synthetic pesticides and fertilizers, but it doesn’t necessarily speak to the product’s effectiveness in promoting height growth.
- FDA Approval
- GMP Certification
- Organic Certification
- Third-Party Testing
Consumers should also be wary of products that claim to be ‘all-natural’ or use terms like ‘herbal remedies’ without any backing by scientific evidence. While natural ingredients are important, they must be combined in a scientifically valid formulation to be truly effective.
The Future of Height Enhancement
Innovations in Growth Supplement Formulations
The landscape of height growth supplements is witnessing a transformative phase with the advent of new formulations that promise enhanced efficacy. Innovative ingredients and delivery methods are at the forefront of this evolution, aiming to optimize the body’s natural growth processes.
Bioavailability is a key factor in the effectiveness of these supplements. Recent developments have focused on improving the absorption of active compounds, ensuring that the body can utilize them more efficiently. This has led to the creation of more potent and faster-acting supplements.
- Advanced encapsulation techniques
- Time-release formulas
- Synergistic ingredient combinations
- Nanotechnology applications
The goal is to provide a product that not only stimulates growth but also supports overall bone health and development.
The market is also responding to consumer demand for transparency and evidence-based products. As a result, many companies are investing in clinical trials to substantiate their claims, leading to a more informed and discerning customer base.
The Role of Genetic Engineering
The advent of genetic engineering has opened new possibilities in the realm of height enhancement. Scientists are now exploring the potential of modifying specific genes associated with growth to overcome limitations set by an individual’s genetic makeup. This approach could revolutionize the way we understand and intervene in the growth process.
While the ethical implications are still being debated, the science behind genetic manipulation for height increase is promising. It involves identifying the genes that regulate bone growth and density, and then using gene-editing tools like CRISPR to make precise alterations.
- Identification of growth-related genes
- Application of CRISPR technology
- Potential for targeted gene therapy
The promise of genetic engineering in height enhancement is not without its challenges, but it represents a frontier in medical science that could offer hope to those seeking to add inches to their stature.
Ethical Considerations and Regulatory Challenges
The pursuit of increased height through supplements raises significant ethical questions. Should individuals alter their natural growth patterns for aesthetic or social reasons? This debate extends beyond personal choice, touching on societal pressures and the potential for height discrimination.
Regulatory bodies face the challenge of ensuring that height growth capsules are both safe and marketed truthfully. The lack of standardization in the supplement industry complicates this task, as companies may make unfounded claims about the effectiveness of their products.
The ethical use of height growth capsules requires a balance between individual autonomy and the protection of consumers from misleading information.
The following points highlight key regulatory challenges:
- Establishing clear guidelines for the advertisement of height growth supplements.
- Monitoring the market to prevent the sale of unapproved or harmful substances.
- Ensuring that consumers have access to accurate information to make informed decisions.
Discover the potential of height enhancement with our cutting-edge solutions. Embrace the future where growth goes beyond genetics, and explore our extensive range of height increase products. From Ayurvedic remedies to nutritional supplements, we have everything you need to reach new heights. Don’t let your stature hold you back any longer. Visit our website now to learn more and take the first step towards a taller you!
Conclusion
In summary, the journey through the science behind height growth capsules has illuminated the complex interplay of genetics, nutrition, and hormonal factors that contribute to human growth. While these capsules offer a beacon of hope for those seeking to increase their stature, it is crucial to approach them with a discerning eye, recognizing the limitations and potential risks involved. The market is replete with products claiming miraculous results, but only through rigorous scientific scrutiny and clinical trials can the efficacy and safety of these supplements be truly ascertained. As we continue to scale new heights in our understanding of human growth, it is imperative that individuals consult healthcare professionals before embarking on any regimen that promises to alter their natural growth patterns. The pursuit of height enhancement must be balanced with the wisdom of evidence-based medicine to ensure the well-being of those seeking to grow taller.
Frequently Asked Questions
What are height growth capsules and how do they work?
Height growth capsules are dietary supplements that claim to support or enhance the natural growth process of the body. They often contain a blend of vitamins, minerals, amino acids, and other ingredients that are believed to stimulate the production of growth hormones or support bone health.
Can taking height growth capsules actually make you taller?
The effectiveness of height growth capsules can vary greatly depending on the individual’s age, genetics, and the specific formulation of the supplement. While some may experience modest increases in height, others may not see any noticeable change.
Are there any side effects associated with height growth capsules?
Some height growth capsules may cause side effects, particularly if they contain hormones or other potent ingredients. Potential side effects can range from mild digestive discomfort to more serious health risks. It’s important to consult with a healthcare provider before starting any supplement regimen.
What is the most important factor in determining how tall I will grow?
Genetics plays a significant role in determining an individual’s height, but environmental factors such as nutrition, overall health, and physical activity during the growth years can also influence growth.
How can I choose a safe and effective height growth capsule?
Look for supplements that have been tested for safety and efficacy, ideally with clinical research to back up their claims. It’s also important to choose products that meet quality and certification standards, and to consult with a healthcare provider.
Is it possible to increase height after puberty?
Height growth is most significant during childhood and puberty when growth plates are still open. After puberty, the growth plates typically close, making significant height increases unlikely. However, some adults may seek out growth hormone therapy or other interventions, though these come with potential risks and should be approached with caution.